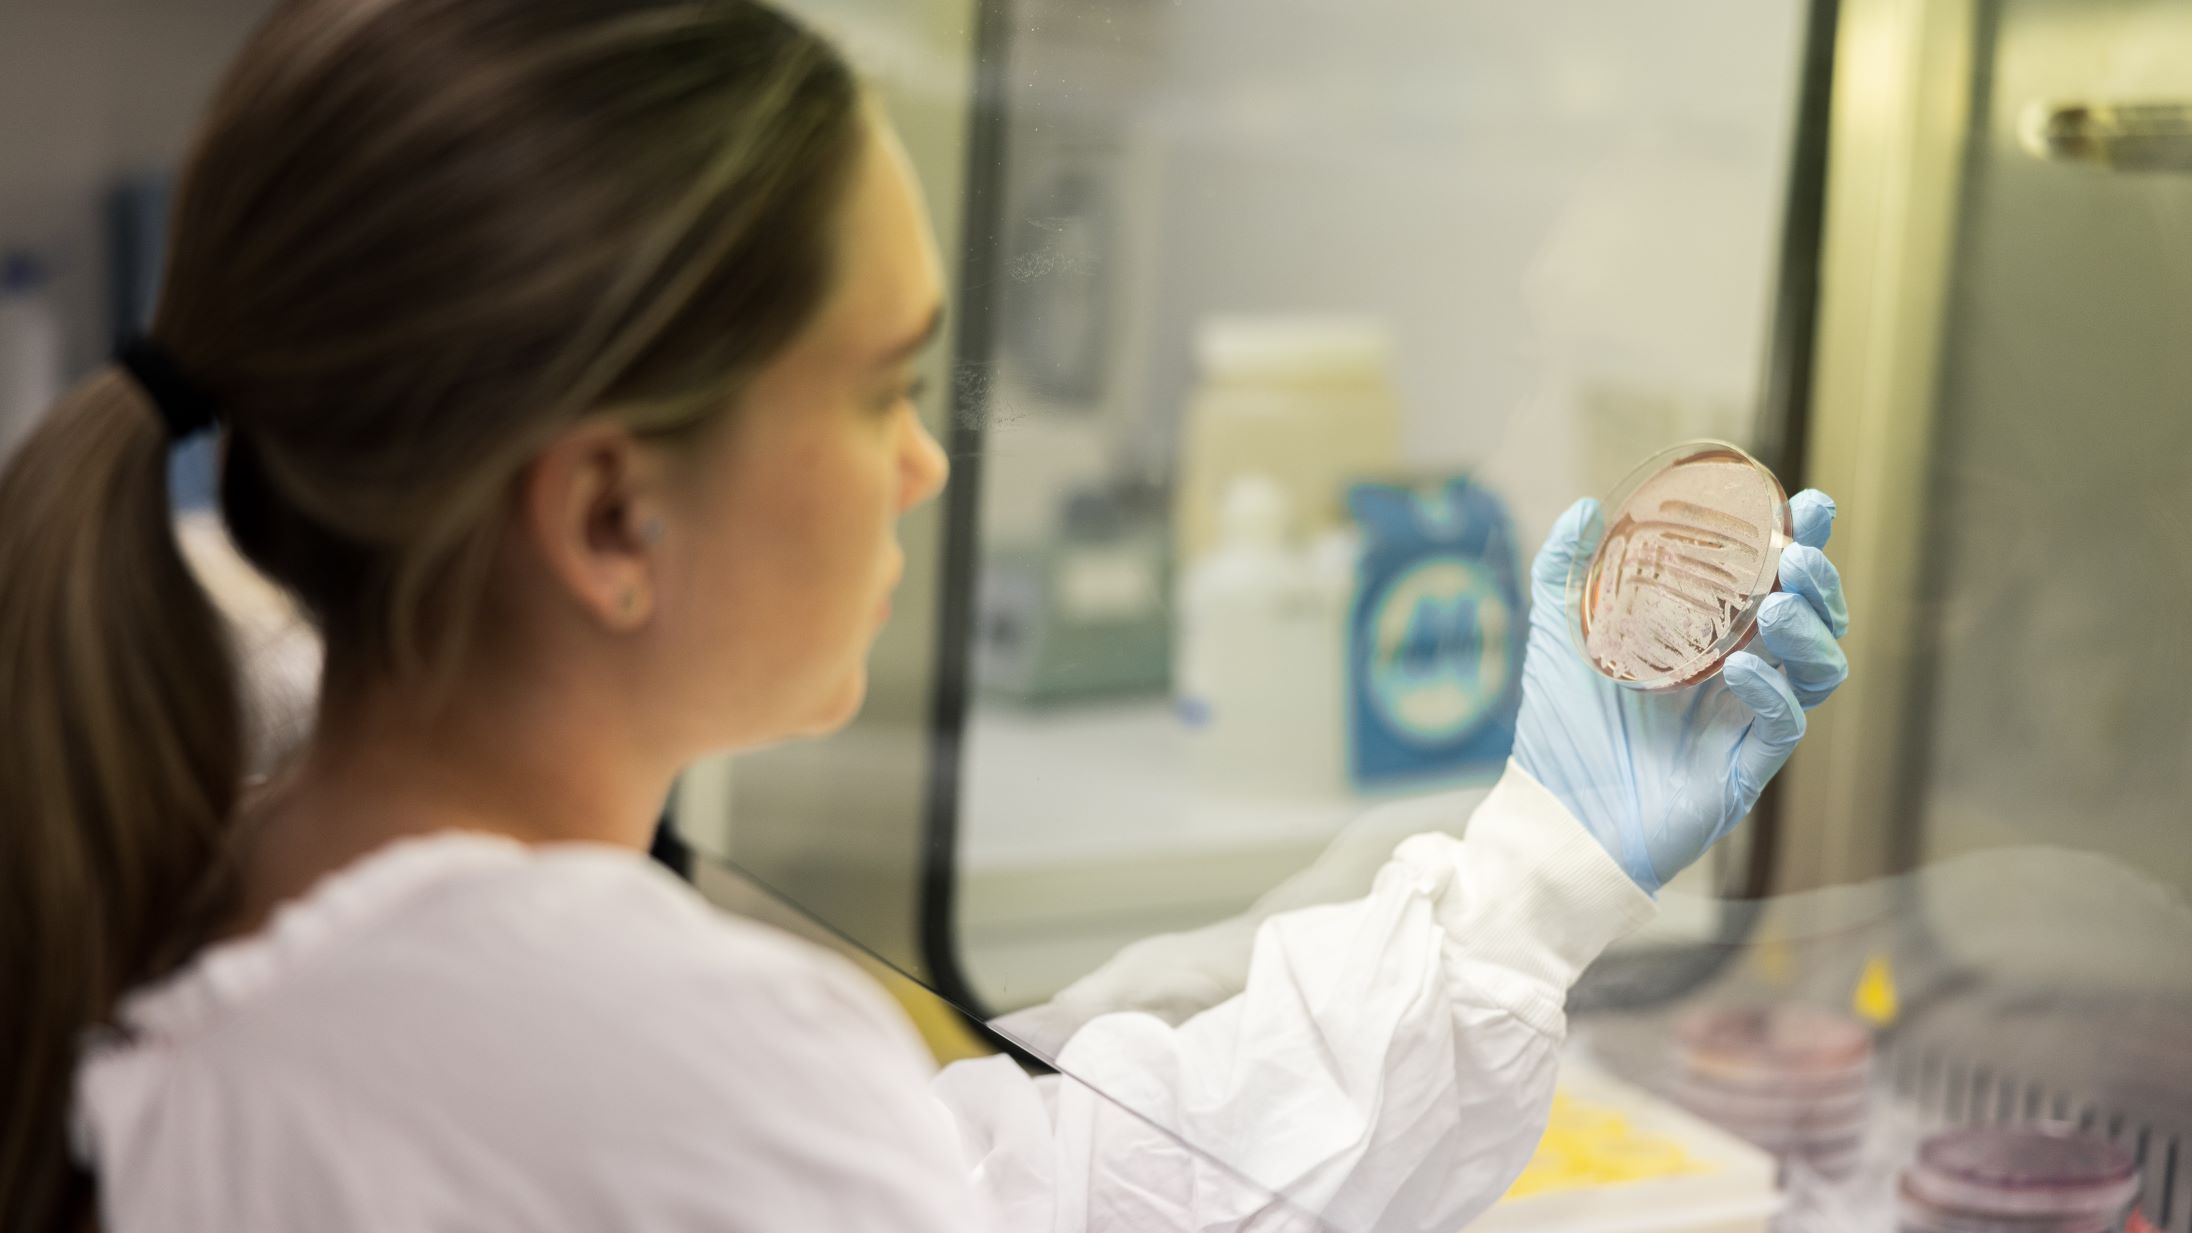
Test Site

Executive Orders
Stay abreast of the executive orders and policy changes that may affect you and the Defense Health Agency. Check back to this page for updates.
We're More Than Healthcare Delivery
Medical Research

Public Health

Medical Education
Mission
The DHA supports our Nation by improving health and building readiness, making extraordinary experiences ordinary and exceptional outcomes routine.
Vision
Unrelenting pursuit of excellence as we care for our joint force and those we are privileged to serve. Anytime, Anywhere – Always.
We're a Global Healthcare Leader
During the COVID-19 pandemic, the healthcare landscape changed dramatically. DHA emerged as a global healthcare leader. The DHA:
- Established a global registry to track COVID-19 cases across the DOD
- Led the DOD vaccine program to keep our beneficiaries safe
- Expanded telehealth services to put our patients' needs first
Working for DHA

Employee Hub

DHA Careers
Person
Person
DHA In Support
9.5 Million
Eligible Beneficiaries
700 + MTFs
Military Treatment Facilities
9 Networks
Nationwide and Worldwide
Leading Global Health Care
During the COVID-19 pandemic, we emerged as a global health care leader, by leading the military medical departments in establishing a vaccination program and policies to distribute and administer initial COVID-19 vaccines to the entire DOD. While the military health landscape changed dramatically during the pandemic, DHA’s most successful actions included operating a global COVID-19 registry, collecting 12,000 units of convalescent plasma, worldwide vaccine delivery, and the expansion of telehealth services across the enterprise.






